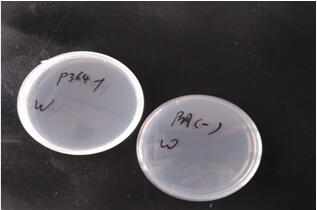
plasmid-preparation2

万千商家帮你免费找货
0 人在求购买到急需产品
- 详细信息
- 询价记录
- 文献和实验
- 技术资料
- 服务名称:
质粒制备
- 提供商:
泓迅科技
除此之外,我们还提供完整、详细的实验记录,保证跟踪和监控整个生产过程;项目管理团队将监控项目全程,确保按时交付。同时,交付产品会有严格的质量控制,包括序列验证、限制酶酶切和内毒素分析等。
 服务优势
服务优势
- 提供研究级和转染级的质粒, < 100EU/mg, <30EU/mg,<5EU/mg三种内毒素水平可选
- 提供从微克到克级别的高通量质粒制备服务
- 质量稳定,批间差小
- 高效的生产过程,准时交付
 实验流程
实验流程

 QC检验
QC检验
| QC项目 | 检测标准 | 检测方法 |
| 外观 | 清澈透明 | 视觉检测 |
| A260/280 | 1.80~2.00 | 紫外分光光度计 |
| 浓度 | 5±0.05 mg/ml | 紫外分光光度计 |
| 超螺旋比例分析 | >95% | 琼脂糖凝胶密度扫描 |
| RNA残余 | 未检出 | 琼脂糖凝胶视觉检查 |
| 基因组DNA | 未检出 | 琼脂糖凝胶视觉检查 |
| 无菌验证 | 48h LB培养基不长斑 | 取0.1 mg样品在LB板孵育48h |
| 限制性酶切分析(可选) | 无杂带 | 酶切后,琼脂糖凝胶电泳分析 |
| 测序验证(可选) | 正确 | DNA测序 |
| 内毒素分析(可选) | <5EU/mg | 内毒素分析试剂盒 |
 服务项目
服务项目
| 研究级别 | 应用级别 | |
| 内毒素水平 | -- | < 100EU/mg, <30EU/mg,<5EU/mg |
| 质量 | 0.1 mg到克级别质粒 | 1 mg到克级别质粒 |
| 周期 | 3个工作日起 | 7个工作日起 |
| QC验证 | 基础QC验证项目 | 基础QC验证项目以及无菌验证、 限制性酶切分析和测序验证 |
| 应用方向 | 1.各种分子生物学的研究和生产,基因克隆,PCR模板,基因文库制作, DNA marker,等 2. 瞬时基因表达,生产少量的研究用蛋白 3.基因存储 4.高等动植物基因改造的工具,基因编辑的工具 5.质粒构建的文库用于大规模基因组研究 |
1.转染实验少量表达目标蛋白,瞬时表达蛋白 2.构建细胞株,长期大量的生产蛋白 3.包装病毒 4.细胞治疗的原材料之一 5.基因治疗的研究 6.超长期基因存储 |
| 发货形式 | 质粒DNA,COA文件,QC报告 | |
 案例分析——制备转染级别质粒
案例分析——制备转染级别质粒
1. 质粒转化后挑取单克隆菌落进行培养;
2. 抽提菌液进行酶切及测序验证,对符合要求的质粒进行大批量接菌抽提;
3. 对各批次抽提质粒进行酶切验证,无误后混合所有抽提质粒;
4. 对大抽质粒进行去内毒素处理,48h细菌检测。
结果
1. 内毒素检测结果为阴性对照不凝固,阳性对照凝固,测试稀释样品不凝固,标准品不凝固,证明去内毒素处理成功。
2. 48h无抗培养基均不长斑,通过无菌检测通过。

图1. 内毒素检测,从左至右依次为阴性对照,阳性对照,测试稀释样品,内毒素检测标准品5EU/mg
图2. 细菌检测结果比对
风险提示:丁香通仅作为第三方平台,为商家信息发布提供平台空间。用户咨询产品时请注意保护个人信息及财产安全,合理判断,谨慎选购商品,商家和用户对交易行为负责。对于医疗器械类产品,请先查证核实企业经营资质和医疗器械产品注册证情况。
- 作者
- 内容
- 询问日期
 文献和实验
文献和实验Preparation of plasmid DNA(质粒制备)
Preparation of plasmid DNA : a modified mini alkaline-lysis/PEG precipitation procedure. ABI
Preparation of plasmid DNA (质粒制备)
Preparation of plasmid DNA : a modified mini alkaline-lysis/PEG precipitation procedure. ABI; 1995 Materials GTE buffer (50mM glucose, 25mM Tris-HCl (pH8.0), 10mM EDTA (pH 8.0)) (200µl/tube) 0.2N NaOH / 1% SDS (freshly made) (300µl/tube) 3.0M
质粒是真核细胞细胞核外或原核生物拟核外能够进行自主复制的遗传单位,是细胞内的一种环状的小分子DNA,作为一个具有自身复制起点的复制单位独立于细胞的主染色体之外。质粒是分子生物学实验中不可缺少的工具载体。高质量的质粒提取是下游试验顺利进行的可靠保证。 质粒制备的方法主要包括以下三个步骤: 细菌的培养及扩增; 细菌的收获和裂解:一般常用碱裂解法。 质粒提取纯化。 做过分子生物学实验的,大多数做抽提过质粒,但不是所有人都知道质粒制备的基本原理。所以我们先介绍一下质粒制备的原理。制备质粒最常
 技术资料
技术资料暂无技术资料 索取技术资料










